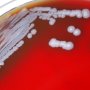

الأمريكيان أمبروس وروفكون يفوزان بجائزة نوبل للطب لعام 2024

أعلنت اللجنة المانحة لجائزة نوبل اليوم الاثنين فوز العالمين الأمريكيين فيكتور أمبروس وغاري روفكون بجائزة نوبل للطب لعام 2024 مناصفة، لاكتشافهما المبدأ الأساسي الذي يحكم كيفية تنظيم نشاط الجينات، وهو الحمض النووي الريبي الدقيق (ميكرو آر.إن.إيه). وأوضحت اللجنة في بيان أن فهم تنظيم نشاط الجينات كان هدفًا مهمًا لعقود، حيث إن تنظيم الجينات بشكل خاطئ قد يؤدي إلى أمراض خطيرة مثل السرطان أو السكري أو أمراض المناعة الذاتية.
وقالت اللجنة إن "الاكتشاف الرائد" سمح بالتعرف على مبدأ جديد تمامًا لتنظيم الجينات، وتبين أنه ضروري للكائنات متعددة الخلايا، بما في ذلك البشر. كما أثبت الحمض النووي الريبي الدقيق (ميكرو آر.إن.إيه) أهميته الأساسية في كيفية تطور الكائنات الحية وعملها.
وتختار لجنة نوبل بمعهد كارولينسكا في السويد الفائزين بجائزة نوبل للطب. وُلد أمبروس عام 1953 في هانوفر بولاية نيو هامبشاير في الولايات المتحدة، وحصل على درجة الدكتوراه من معهد ماساتشوستس للتكنولوجيا (إم آي تي)، وهو الآن أستاذ للعلوم الطبيعية في كلية الطب بجامعة ماساتشوستس.
في المقابل، وُلد روفكون في بيركلي بولاية كاليفورنيا في الولايات المتحدة عام 1952، وحصل على درجة الدكتوراه من جامعة هارفارد عام 1982. وأصبح باحثًا رئيسيًا في مستشفى ماساتشوستس العام وكلية الطب بجامعة هارفارد عام 1985، ويعمل حاليًا أستاذًا لعلم الوراثة.
للمزيد تابع خليجيون نيوز على: فيسبوك | إكس | يوتيوب | إنستغرام | تيك توك